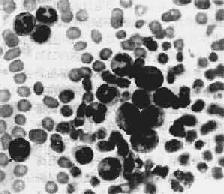
ϸ԰Ѫ

二、慢性白血病
慢性白血病起病缓慢,病程长,早期多无明显症状。有些病人在体格检查或因其他疾病就诊时发现。主要症状为乏力、消瘦、发热、脾肿大等。
慢性白血病按细胞来源分为慢性粒细胞白血病(CML)和慢性淋巴细胞白血病(CLL)。
CML来源于多能髓样干细胞。瘤细胞的成分以幼粒细胞为主。骨髓和脾内幼稚粒细胞明显增多。与急性白血病不同,CML时髓样干细胞仍具有分化成熟的能力,周围血内可见大量成熟的粒细胞。原始粒细胞的异常增生与分化,可能与干细胞对调节造血细胞生长分化的反馈信号反应不足有关。
CML病人中约90%伴有一种染色体异常,称为Ph1染色体,已确定为CML的标记染色体。Ph1染色体指22号染色体的长臂易位至9号染色体长臂。Ph1染色体的存在与CML的发生发展有关。典型的CML时Ph1阳性,多见于青壮年,化疗效果好。Ph1阴性的CML多见于老人和小儿,预后不佳。
CLL为小淋巴细胞恶变而来。绝大多数CLL来源于B细胞,T细胞性CLL很少见。恶变的B细胞无免疫功能,不能转化为浆细胞,病人常有低丙种球蛋白血病。有时CLL与小淋巴细胞淋巴瘤不易区别。
【病理变化】
1.周围血像周围血白细胞显著增多,数量正常或减少者少见。CML时白细胞增多尤为明显,多在10万~至80万/μ1之间,少数甚至可超过100万,其中大多数为较成熟的中、晚幼和杆状核粒细胞,早幼粒和原粒细胞很少(图11-7)。嗜碱性和嗜酸性粒细胞也增多。CML时中性粒细胞内碱性磷酸酶常缺如或降低。这点有助于与类白血病反应相区别。CLL血白细胞总数多在3万~10万/μ1之间。血像单一,绝大多数为成熟的小淋巴细胞,只有少数幼淋巴细胞。慢性白血病早期贫血较轻,血小板无明显减少。CML时血小板常增多。晚期有明显贫血和血小板减少。
图11-7 慢性粒细胞性白血病
周围血内白血病细胞主要为中幼粒细胞
2.骨髓 CML时骨髓增生活跃,各期粒细胞均可见到,以中、晚幼粒和杆状粒细胞占优势,幼红细胞和巨核细胞早期可增生,血小板增多,晚期则被抑制。CLL骨髓内淋巴细胞增多,可呈结节状或弥漫性浸润,主要为成熟的小淋巴细胞,原及幼淋巴细胞很少。粒、红、巨核细胞系及血小板均减少。
3.淋巴结 CLL时淋巴结明显肿大。早期淋巴结可活动,晚期瘤细胞浸润包膜,肿大的淋巴结常相互融合,并与周围组织粘连。切面灰白色鱼肉状。镜下可见淋巴结内有大量瘤细胞浸润,严重者淋巴结构破坏消失。CML时淋巴结轻至中度肿大,不如CLL明显。
4.脾 脾多明显肿大,CML最显著,可达4000~5000g。肿大的脾占据腹腔大部,甚至可达盆腔。红髓脾窦内有大量白血病细胞浸润,可压迫血管引起梗死。CLL时,脾肿大不如CML时严重,一般不超过2500g。肿大的脾包膜增厚,常有纤维性粘连,质较硬,切面暗红色,脾小体不明显,呈均质状。镜下见大量白血病细胞浸润,CLL时主要累及白髓,严重者白血病细胞弥漫浸润,脾小体和脾髓结构消失。
5.肝肝中度肿大,表面光滑。镜下,各型白血病的浸润方式不同。CLL时,瘤细胞多浸润于汇管区及其周围;CML时,瘤细胞多沿肝窦呈弥漫性浸润。
此外,慢性白血病时,白血病细胞并常浸润胃肠、心、肾、皮肤等全身器官和组织。白血病细胞浸润处可破坏相应的组织和器官而引起出血、感染等继发性变化。
慢性白血病病变发展缓慢,病程较长。开始约2~3年病情稳定,对化疗有效,有时稳定期可达10年以上。以后治疗无效,病情加重。CML最后常发生急性变,突然出现原因不明的高热,脾迅速肿大,贫血、血小板减少,出血症状加剧,骨及关节疼痛,骨髓和血中原粒和早幼粒细胞突然增加。急性变发生后病情常急转直下,预后很差。CLL发生急性变者极少。CLL患者平均寿命比CML长,最后多因低丙种球蛋白血症,免疫功能低下并发感染而致死。
【类白血病反应】
类白血病反应(leukemoid reaction)通常是由于严重感染、某些恶性肿瘤、药物中毒、大量出血和溶血反应等刺激造血组织而产生的异常反应,表现为周围血中白细胞显著增多(可达50,000/μ1以上),并有幼稚细胞出现。类白血病反应的治疗和预后均与白血病不同。一般根据病史、临床表现和细胞形态可以与白血病鉴别,但有时比较困难。类白血病反应有以下特点可协助鉴别:①引起类白血病反应的原因去除后,血像可恢复正常;②类白血病反应时,一般无明显贫血和血小板减少;③类白血病反应时,粒细胞有严重毒性改变,胞浆内有毒性颗粒和空泡等;④类白血病反应时,中性粒细胞的碱性磷酸酶活性和糖皆明显增高,而粒细胞白血病时,两者均显著降低;⑤慢性粒细胞白血病细胞内可见Ph1染色体,类白血病反应时则无。
| 上一页:一、急性白血病 |
| 当前页:二、慢性白血病 |
| 下一页:三、毛细胞白血病 |